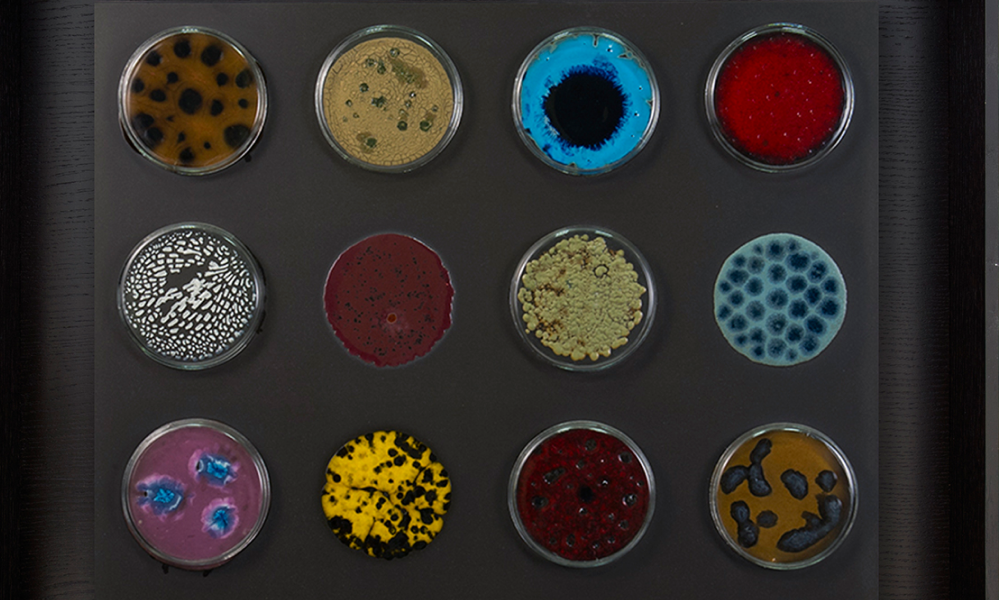

5 современных керамистов, чьи работы показывают в музеях
Керамика — специальный вид искусства. Лепка из глины была одним из первых ремесел, освоенных человечеством, и, несмотря на то что многие сосуды принимали участие в священных церемониях, абсолютное большинство горшков, кувшинов, киликов, стаканов и прочих сосудов были утилитарными предметами. Их ценность заключалась в том, что они помогали готовить еду, есть, пить, запасать воду, поливать цветы и так далее.
Все изменилось с расцветом археологии во второй половине XIX века, когда керамика оказалась важнейшим свидетельством материальной культуры человечества: ее стали изучать и коллекционировать. С того же времени различные художественные течения, включая «Искусства и ремесла» в Британии и Абрамцевский кружок в России, увлеклись декоративными произведениями и открыли для себя лепку и гончарное мастерство. Выяснилось, что многие художники, чьи картины и скульптуры были признаны шедеврами при их жизни, также хороши в работе с майоликой, фаянсом, глазурью и фарфором. Михаил Врубель, Константин Сомов, Александр Головин, Фернан Леже, Жоан Миро, Пабло Пикассо делали вещи, которые хранят музеи по всему миру. Керамика поменяла статус, перестав быть исключительно ремеслом, и стала искусством, родственным скульптуре и даже архитектуре — когда ее используют для украшения парков или в качестве декоративных элементов интерьера.
Спор о том, что в керамике важнее — польза и красота, ведется где-то параллельно в мастерских с середины XX века. Ваза для цветов или цветы для вазы? Насколько можно трансформировать идею классической красоты в этом материале? Как ведет себя абстракция в керамике? Эти вопросы не помешали ей в последние пару лет снова попасть в центр внимания и стать модной на волне популярности модернизма 1960-80-х. У художников есть множество ответов на них, и познакомиться с ними можно на обширной выставке в «Царицыно». Мы же предлагаем посмотреть на искусство пяти художников-керамистов на BURO. и узнать, как они воспринимают свое искусство.

Елена Хлендовска
Работы в музеях: ММСИ на Петровке, Раменский художественный музей, музей-заповедник «Царицыно»
«Я училась в математической школе, участвовала в олимпиадах по биологии, готовилась к поступлению в МГУ. Но однажды на даче, где мы вечно играли в какие-то «казаки-разбойники», отец моей подружки, архитектор, видя, как я мастерю всем бусы из ракушек, бросил: «А у тебя способности». Неожиданно его слова попали в самое сердце. Спустя какое-то время, ни с кем не посоветовавшись, я бросила подготовительные курсы в университете и нашла преподавателя в художественном училище памяти 1905 года. Он подготовил меня к поступлению в Строгановку. Помню первый день в академии — я опоздала, всех первокурсников уже увели на знакомство с музеем декоративно-прикладного и промышленного искусства, — а я будто провалилась куда-то, потеряла связь с реальностью. Так до сих пор и живу. Смотрю на свои студенческие фотографии: все в телогрейках, заляпанных фартуках, резиновых сапогах, счастливые. Круг общения всегда был очень узким — только художники. Со сторонними людьми никогда не получалось. Они считали, что я занимаюсь какой-то ерундой.
Занятие керамикой — дорогое развлечение. Кисти, краски, печь, сама глина — все это стоит немалых денег. Свою первую печь для обжига я собрала собственными руками — работает до сих пор. У нее молибденовые стержни в качестве нагревательных элементов и нет дверцы, но я приспособила под это дело кирпич. У меня всегда было много новых работ, и я участвовала во всех выставках подряд — как потом оказалось, с удовольствием. Потому что это важно — видеть, как твоя работа собирает пространство вокруг себя, как небольшая тарелочка с птицей наполняет энергией зал».





Наталия Хлебцевич
Работы в музеях: Всероссийский музей декоративно-прикладного и народного искусства, Музей керамики и «Усадьба Кусково ХVIII века», Елагиноостровский музей русского декоративно-прикладного искусства и интерьера (Санкт-Петербург), Музей МГХПА им. С. Г. Строганова, Музей архитектурного образования Москвы при МАРХИ
«Мне казалось, что Строгановка — это для гениев. Туда всегда был очень большой конкурс, и с первого раза поступали редко. Я стала студенткой на третий год — и была абсолютно счастлива. Обычно, когда меня спрашивают, чем конкретно я занимаюсь, я отвечаю — скульптурой. Потому что большинство людей все еще думают, что керамика — это чашки и плошки. Да и я не на 100% керамист! Моя керамика не декоративного свойства. Я пытаюсь работать на той стороне современного искусства, где больше смыслов. Люблю работать с живыми организмами: у меня были проекты с ростками тыквы, грибами-вешенками, куриными яйцами, крысами и даже тараканами. С последними была целая история. В 1990-е у нас на кафедре водились тараканы — они плодились со страшной силой, их было никак не вывести, они были везде. Меня попросили подготовить подарок — памятную тарелку, на которой бы все сотрудники кафедры расписались. Я взяла большое фарфоровое блюдо, мы все расписались, и я оставила ее на ночь сушится. Прихожу утром, а блюдо — чистое! И тут меня осенило: надглазурную краску смешивают с сахарным сиропом, тараканам было просто очень вкусно. Я этот случай, конечно, запомнила на всю жизнь, а спустя годы, сначала в галерее А3, а потом и в Дарвиновском музее сделала проект «Между строк» — о пустоте. Фарфоровые пластины с нанесенным на них надглазурным текстом опускали в боксы с мадагаскарскими тараканами, они подъедали часть букв, частично уничтожая написанное. Потом я обжигала пластины, делая тараканов своими соавторами. Теперь, когда меня спрашивают, как я придумываю свои проекты, я обычно рассказываю эту историю.
Мне нравится работать с «вечными» темами. Знаю, керамика сегодня старается реагировать на остросоциальные вопросы, но мне лично кажется, что все это слишком преходящее для такого древнего материала, как глина».

Василий Шлычков и Елена Малявина
Работы в музеях: музей-усадьба «Кусково»
«Керамика — мой случайный выбор. Я учился в Екатеринбурге на монументальной живописи. Как-то поехал с товарищем в Питер и за компанию с ним поступил в Муху (Высшее художественно-промышленное училище им. Штиглица. — Прим. ред.) на художественные керамику. В Мухе, кстати, я познакомился со своей будущей женой Леной Малявиной, которая потом перевелась в Строгановку. Ну и я за ней. Так с тех пор мы делим авторство пополам — даже если параллельно делаем какие-то разные вещи, подписываемся все равно вместе. У нас были перерывы — то на мою армию, то на анимацию, то еще на что-то, — но керамика всегда проходит красной линией, за которую мы держимся. В отличие от меня, Лена захватила ту эпоху, когда студентов отправляли на практику на большие керамические производства — например, на завод в Конаково. Очень печально, что вместе с заводами и большими мастерскими исчезли традиции и привычное формирование изобразительного языка. Раньше люди, занимающиеся керамикой, развивались в одном направлении. Сейчас этот процесс больше напоминает мозаику — все разрознены.
Лет 10 назад мы с группой российских керамистов были в Китае. Мы жили и работали там больше месяца. Китай — одна из тех стран, где традиции выживают естественным путем. Европа — нет, там искусство всегда переходит на новый виток. И если сравнивать Россию с Китаем и Европой, то мы, конечно, глубокая Азия. Но, на мой взгляд, это не так уж и плохо. Конечно, керамические традиции у нас не такие глубокие как в Китае или Японии. С нашим народным промысловым творчеством — низкообжиговым, нутряным — мы связь потеряли очень давно. Сегодня к этому всему музейное отношение — мы идем в музей, видим глиняные игрушки, восторгаемся ими, но все эти чувства лишены естественных корней. И хочется отметить, что именно традиции дают твердую почву для глубокого и яркого развития искусства. И очень жаль, что мы это почти утратили.
Но есть и хорошие новости. Вообще, каждый раз художник, когда берет свой инструмент — кисть, молоток, скребок, что угодно, — хочет сделать что-то новое. А сегодня к этому прибавилось еще и новое отношение к выставкам, которые стали отдельным видом искусства. Момент игры должен присутствовать всегда и везде».





Анастасия Чарина
Работы в музеях: Арт-центр им. Марка Ротко (Даугавпилс, Латвия), Галерея национального декоративно-прикладного искусства (Минск, Беларусь)
«С керамикой я с детства. Я выросла в семье художников, один из которых был керамистом — а именно моя мама. Она училась в Мухе, где впоследствии учились и я, и сестра. Год перед поступлением я проработала лаборантом на кафедре керамики. И сразу укрепилась в мысли, что работать буду только с глиной. Мне все в ней нравится: блестящая поверхность, гибкость, вязкость. Обывателям сложно понять, чем я занимаюсь. Стандартный разговор с новыми знакомыми всегда примерно такой: “Кем работаешь?” — “Я художник”. — “Картины пишешь?” — “Нет, я работаю с глиной”. — “А, ясно, горшки что ли?” Рассказывать, что такое концептуальная керамика, — неблагодарное занятие. Поэтому в ответ я обычно просто показываю свой инстаграм. Частая реакция на увиденное: «Фига себе, это тоже керамика?»
Было время, когда я, как многие керамисты, увлекалась природными объектами. Ведь это очень естественно — создавать из глины что-то растительное, живое. Но в 2016 году я на год по семейным обстоятельствам переехала в город Череповец. Это стало переломным моментом в моем творчестве. Город не отличается экологичностью. Треть его — заводы, а горизонт — столбики разнооттеночных дымов. В хорошую погоду ими даже удавалось любоваться. Дым стал для меня некой субстанцией, из которой рождались образы. И я начала его лепить... Потом я вернулась в Петербург и на волне экологической тематики стала лепить мусор. Просто так — ради пробы, ещё не понимая, во что это выльется. Так, малыми порциями родилась на свет «Береговая линия». Часть её как-то выставлялась в одной небольшой галерее, кураторы которой предупреждали меня, что какие-то детали могут исчезнуть в карманах любопытных посетителей. Но получилось наоборот. После прошедшего в соседнем зале корпоратива, я обнаружила в композиции пару новых объектов — гости дополнили ее фантиками от конфет. Меня это даже порадовало — такой неожиданный месседж от зрителя всегда ценен».





Екатерина Сухарева
Работы в музеях: Елагиноостровский музей-дворец, Музей искусства Санкт-Петербурга ХХ–ХХI веков, Радищевский музей (Саратов), Новосибирский государственный художественный музей
«Мои родители — известные художники-керамисты (Александра Задорина и Наталия Савинова. — Прим. BURO.). Мне всегда хотелось быть как они. Работа с утра до вечера, много друзей, ощущение успеха — все это было привлекательно для меня. При этом я не была ребенком, который путается под ногами взрослых, ночует в мастерской. Чаще обычного проводила время с бабушкой и училась в школе при Академии художеств. И всегда знала, что буду заниматься изобразительным искусством.
Помню выражение “уехал в группу”. Сейчас оно мало кому понятно. Когда-то именно так называлась творческая командировка для художников, которым предоставлялась возможность два месяца прожить в Прибалтике, в Дзинтари на полном обеспечении — и материальном, и пищевом. Ни о чем не беспокоясь, они работали, общались, у них были хорошие обжиги, а после — выставка. Это была такая прекрасная, почти литературная история: отличная техническая база, возможность перенять новые методы у людей из других керамических школ, потому что на такие сборы люди приезжали со всего СССР. Последний раз “в группу” родители ездили в 1990-м.
Надо сказать, что в советское время художники-прикладники были обеспечены лучше, чем другие представители творческой интеллигенции. При строительстве любого дома культуры, ТЮЗа или ресторана в Сыктывкаре, Перми, Новосибирске, где угодно соблюдался закон: “под красоту” отпускалось 3% от общей сметы, а это были воистину колоссальные деньги. Жаль, что от всей этой красоты мало что не осталось.
Я — вполне традиционных взглядов художник. Совсем не контемпорари. Занимаюсь фигуративной керамикой — в основном скульптурой. Меня интересует человек, его состояние, его жизнь. И еще я всегда думаю о том, где конкретно окажется моя работа, с кем она будет рядом. Мне важны впечатления, настроения ее будущего обладателя. И потому стараюсь какие-то веселые штуки в работу вставлять, чтобы он это почувствовал.
Многое изменилось за последние тридцать лет. К примеру, у каждого, кто сейчас занимается керамикой, есть собственная печь. И это как масло по воде потекло — не вглубь, а вширь. Керамикой могут пробовать заниматься все. Но образование в нашем деле — очень немаловажно. Хочешь купить печку — купи. Но легко не получится».




Статьи по теме
Подборка Buro 24/7